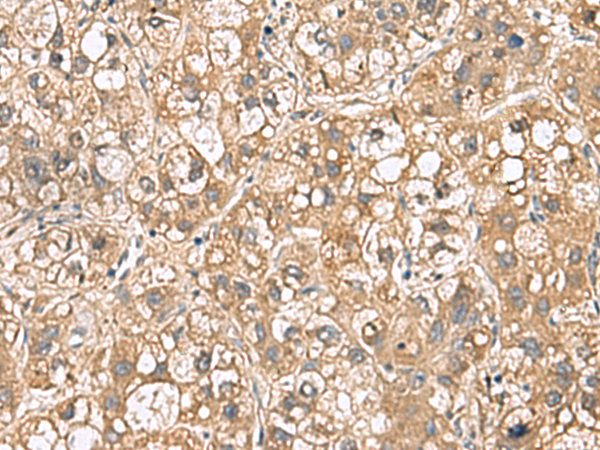

中文名稱:兔抗PTPRS多克隆抗體
英文名稱: Anti-PTPRS rabbit polyclonal antibody
別 名: protein tyrosine phosphatase, receptor type S; R-PTP-S; PTPSIGMA; R-PTP-sigma
相關(guān)類別: 一抗
儲 存: 冷凍(-20℃)
宿 主: Rabbit
抗 原: PTPRS
反應(yīng)種屬: Human, Mouse, Rat
標(biāo)記物: Unconjugate
克隆類型: rabbit polyclonal
Background:
The protein encoded by this gene is a member of the protein tyrosine phosphatase (PTP) family. PTPs are known to be signaling molecules that regulate a variety of cellular processes including cell growth, differentiation, mitotic cycle, and oncogenic transformation. This PTP contains an extracellular region, a single transmembrane segment and two tandem intracytoplasmic catalytic domains, and thus represents a receptor-type PTP. The extracellular region of this protein is composed of multiple Ig-like and fibronectin type III-like domains. Studies of the similar gene in mice suggested that this PTP may be involved in cell-cell interaction, primary axonogenesis, and axon guidance during embryogenesis. This PTP has been also implicated in the molecular control of adult nerve repair. Four alternatively spliced transcript variants, which encode distinct proteins, have been reported.
Applications:
ELISA, IHC
Name of antibody:
PTPRS
Immunogen:
Fusion protein of human PTPRS
Full name:
protein tyrosine phosphatase, receptor type S
Synonyms:
R-PTP-S; PTPSIGMA; R-PTP-sigma
SwissProt:
Q13332
ELISA Recommended dilution:
5000-10000
IHC positive control:
Human liver cancer and Human tonsil
IHC Recommend dilution:
100-300
技術(shù)規(guī)格

購物車
幫助
021-54845833/15800441009
